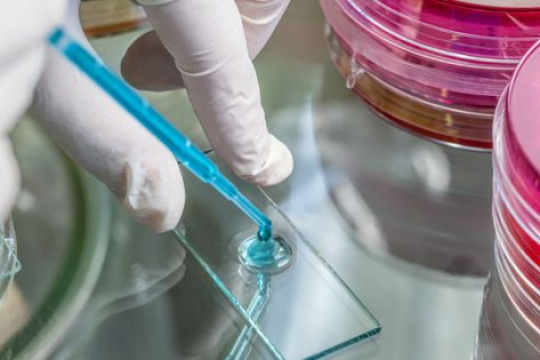
image

ReviewAZ tự hào là đơn vị được hơn 150 công ty, doanh nghiệp trong và ngoài nước tin dùng và lựa chọn
để giúp tăng đánh giá và tạo tín cho doanh nghiệp trên không gian số.Hơn 150+ công ty tin dùng








Sở hữu công nghệ tiên tiến kèm thuật toán tối ưu Lượng đánh giá hoàn toàn từ người dùng thật Chúng tôi mang đến bạn những tùy chỉnh linh hoạt theo nhu cầu Chỉ cần những thao tác đơn giản là bạn đã giúp doanh nghiệp của bạn thêm uy tín Với đội ngũ hỗ trợ mạnh mẽ chúng tôi tự tin giúp đỡ bạn mọi lúc.Sự khách biệt mà chúng tôi có!
chúng tôi tự tin mang đến cho bạn những đánh giá chất lượng và tự nhiên nhất.
An toàn

Tùy chỉnh

Đơn giản

24-7 Support

Tự hào là đơn vị mang đến cho cho các doanh nghiệp dịch vụ tăng đánh giá tốt nhất. Chúng tôi đã và đang phát triển một cách mạnh mẽ.
Hãy cùng xem các con số dữ liệu mà chúng tôi đã hoàn thành dưới đây.
0M+ Download 0 M+ Followers 1500+ Reviews 0+ Countries

Những con số ấn tượng.
TRẢI NGHIỆM NGAY




Chỉ với 3 bước cực kỳ đơn giản bạn đã có thể tạo ngay chiến dịch và bắt đầu tạo chiến dịch đầu tiên để tăng đánh giá. Tiến hành thanh toán và tận hưởng gia tăng uy tín của doanh nghiệp bạn thôi nào!Làm thế nào? - 3 bước đơn giản
để tăng đánh giá giúp doanh nghiệp của bạn thêm uy tín trên không gian số.
01

Tạo chiến dịch
Đăng nhập vào tài khoản
02

Thanh toán và tận hưởng
Các câu hỏi thường gặp FAQs
03

Được tin tưởng bởi rất nhiều doanh nghiệp trong và ngoài nướcKhách hàng nói gì?
hãy xem khách hàng nói gì về chúng tôi dưới đây
Tại ReviewAZ chúng tôi luôn cam kết có mức giá rẻ nhất thị trường giúp bạn luôn hài lòng. Content tự động AI Hỗ trợ Tiếng Việt - Tiếng Anh Không kèm hình ảnh Content hệ thống AI Hỗ trợ Tiếng Việt - Tiếng Anh Hình ảnh do bạn cung cấp Hỗ trợ 24/7 Content cung cấp Kèm hình ảnh tự úp Hỗ trợ Tiếng Việt - Tiếng Anh Hỗ trợ 24/7Các gói review

Cơ bản
Phù hợp giá rẻ
CHỌN NGAY

Phổ biến
Phù hợp doanh nghiệp
CHỌN NGAY

Cao cấp
Dành cho VIP
CHỌN NGAY
Nếu bạn gặp bất kỳ vấn đề nào trong quá trình sử dụng, Có! Chúng tôi luôn bảo hành dịch vụ review 1-1 cho bạn nếu các review bạn đã book bị die hoặc không tìm thấy. Bạn có thể kiểm tra các review tại mục thống kê trong quản lý tài khoản của mình. Có! Chúng tôi luôn hỗ trợ doanh nghiệp một cách tốt nhất. Bạn chỉ cần lựa chọn gói review nội dung tự upload để sử dụng theo ý muốn của mình. Bạn đừng lo lắng, với hệ thống AI mà ReviewAZ sử dụng sẽ giúp bạn hoàn toàn có thể chủ động trong việc tạo nội dung review một cách tự động và chính xác nhất. Bạn có thể lựa chọn các gói theo yêu cầu mà chúng tôi cung cấp. Nếu bạn muốn các review kèm theo hình ảnh thì bạn có thể lựa chọn gói review kèm hình ảnh và tải hình ảnh bạn muốn lên trong quản lý chiến dịch của mình.FAQ - Các câu hỏi thường gặp
hãy tham khảo một số câu hỏi thường gặp dưới đây
Trái ngược với truyền thống văn hóa khiêm tốn, nhiều người có thói tự phụ, luôn coi thường người khác,... Sức khỏe là mối quan tâm lớn nhất đối với tất cả mọi người. Trong các dịch vụ chuyên khoa... Xét nghiệm là một trong những yếu tố quan trọng để chẩn đoán bệnh một cách chính xác nhất. AFB... Trong công việc và học tập hiện nay đang du nhập và sử dụng rất nhiều từ chuyên ngành tiếng... Approved là một từ khá thường gặp trong các lĩnh vực khác nhau của đời sống. Tuy nhiên cũng do... Amater được sử dụng trong cuộc sống hàng ngày hoặc trên các trang mạng xã hội. Từ này có nguồn...Tin tức mới nhất
 2 tháng trước
2 tháng trước
Tự phụ là gì? Tự phụ là tính tốt hay xấu?
 2 tháng trước
2 tháng trước
Anti Hbs là gì? Mục đích của việc xét nghiệm Anti Hbs?
2 tháng trước
2 tháng trước
AFB là gì? Đối tượng nào phải tiến hành xét nghiệm?
 2 tháng trước
2 tháng trước
Abstract là gì? Các cách để viết một bản Abstract hoàn chỉnh
 2 tháng trước
2 tháng trước
Approved là gì? Ý nghĩa thường gặp trong các lĩnh vực khác nhau
 2 tháng trước
2 tháng trước
Amater là gì? Người amater có những biểu hiện gì?















